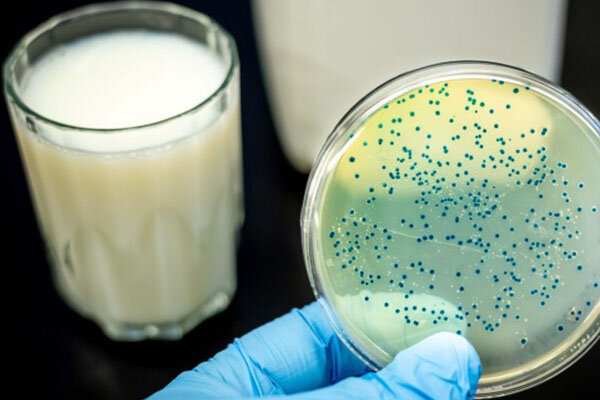

تب مالت همچنان قربانی میگیرد؛ بیش از ۲۰ هزار مبتلا در سال

علیرضا باهنر استاد دامپزشکی تهران در گفتگو با خبرنگار خبرگزاری مهر گفت: بیماری تب مالت از جمله بیماریهای مشترک بین انسان و دام است، در کشور ما همچنان یکی از چالشهای جدی حوزه سلامت عمومی و دامپزشکی محسوب میشود. هرچند این بیماری در بسیاری از کشورها کنترل یا حتی ریشهکن شده، اما ایران همچنان با آمار نگرانکنندهای از ابتلاء مواجه است؛ بهویژه در مناطق روستایی و دامپرور نیز بیشتر است.
وی افزود: بر اساس آمارهای رسمی، سالانه بیش از ۲۰ هزار نفر در کشور به این بیماری مبتلا میشوند؛ عددی که بسیاری از کارشناسان حوزه سلامت معتقدند آمار واقعی بهمراتب بیشتر از آن است. این بیماری نه تنها باعث مشکلات جدی برای مبتلایان از جمله تب، درد مفاصل، اختلالات قلبی و مشکلات مزمن میشود، بلکه بار سنگینی را بر دوش سیستم بهداشت و درمان میگذارد.
گروههای پرخطر و راههای انتقال
به گفته باهنر؛ این بیماری به طور عمده از دو طریق انتقال مییابد؛ نخست افرادی که بهصورت شغلی با دامها در تماس هستند مانند دامداران، دامپزشکان و کارگران کشتارگاهها. دوم، مردم عادی که فرآوردههای لبنی سنتی و غیربهداشتی مانند شیر خام، پنیر محلی، خامه و بستنی سنتی مصرف میکنند و تماس مستقیم با دام آلوده، جنین سقطشده دام و عدم رعایت اصول بهداشتی در دامداریها از مهمترین عوامل انتقال این بیماری محسوب میشود.
واکسیناسیون دام و فرهنگسازی مصرف ایمن
وی ادامه داد: برای پیشگیری مؤثر، باید پوشش واکسیناسیون دامها بهویژه در مورد گوسفند، بز، گاو و گوسالهها به طرز قابلتوجهی افزایش یابد. در کنار آن، ارتقا بهداشت در دامداریها و نظارت مستمر بر تولید، عرضه و توزیع فرآوردههای لبنی از اهمیت بالایی برخوردار است.
باهنر خاطرنشان کرد: همچنین، فرهنگسازی در خصوص مضرات مصرف لبنیات سنتی بدون جوشاندن یا فرآیند بهداشتی ضروری است و برخلاف باور عمومی، شیر و فرآوردههای لبنی پاستوریزه کارخانهای تحت نظارت دقیق دامپزشکی و وزارت بهداشت قرار دارند و از نظر سلامت، گزینهای بسیار ایمنتر برای مصرف هستند.
لزوم ورود جدی رسانهها و نهادهای سیاستگذار
وی ادامه داد: با توجه به پیامدهای اقتصادی و بهداشتی تب مالت، بسیاری از کارشناسان خواستار ورود رسانهها به این موضوع و برگزاری میزگردهای تخصصی با حضور نمایندگان وزارت بهداشت، سازمان دامپزشکی، اساتید دانشگاه و فعالان حوزه سلامت هستند و شفافسازی، آموزش عمومی و مطالبه گری از نهادهای مسئول، میتواند به کاهش چشمگیر ابتلاء و خسارت ناشی از این بیماری کمک کند.
باهنر در پایان گفت: تب مالت تنها یک بیماری عفونی نیست؛ بلکه نمادی از چالشهای بهداشتی، فرهنگی و اقتصادی کشور است که مقابله با آن، نیازمند عزمی ملی و همافزایی همهجانبه دستگاهها و مردم خواهد بود.





